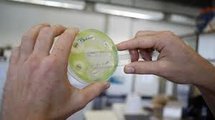

"Il y a urgence d'une part à mettre en place un système de surveillance international dans les prochains mois, et d'autre part à tester tous les patients admis dans un système de santé" dans le plus grand nombre possible de pays, a expliqué le Dr Patrice Nordmann, de l'Hôpital Bicêtre près de Paris dans une entretien avec l'AFP.
Le Dr Nordmann participe à la 50e conférence annuelle de l'ICAAC (Interscience Conference on Antimicrobial Agents and Chemotherapy), plus grand colloque sur les maladies infectieuses qui réunit du 12 au 14 septembre quelque 12.000 spécialistes à Boston (Massachusetts, nord-est).
"Ces mesures ont déjà été décidées en France et sont discutées très sérieusement au Japon, à Singapour et en Chine", a précisé le Dr Nordmann.
"Pour l'instant on ne sait pas encore la rapidité d'expansion du phénomène (...), s'il s'agit de mois ou d'années, mais ce qui est certain c'est que ça va se diffuser (...), c'est un peu comme une bombe à retardement", a-t-il dit, soulignant l'énorme réservoir que représentent pour ce pathogène les 1,3 milliard d'habitants du sous-continent indien et leur importante diaspora.
Ce "super-pathogène" appelé NDM-1 (New Delhi metallo-lactamase-1) est apparemment originaire d'Inde et a été détecté pour la première fois en 2007 en Grande-Bretagne.
Il est venu à l'attention des médias à la suite d'une étude publiée en août dans la revue médicale britannique The Lancet.
Cette recherche expliquait que ce nouveau pathogène a été ramené en Grande-Bretagne par des "médico-touristes" (patients se faisant opérer à l'étranger) revenant d'Inde.
Un Belge hospitalisé au Pakistan à la suite d'un accident de voiture est la première personne connue à ce jour à y avoir succombé.
js/cel
Le Dr Nordmann participe à la 50e conférence annuelle de l'ICAAC (Interscience Conference on Antimicrobial Agents and Chemotherapy), plus grand colloque sur les maladies infectieuses qui réunit du 12 au 14 septembre quelque 12.000 spécialistes à Boston (Massachusetts, nord-est).
"Ces mesures ont déjà été décidées en France et sont discutées très sérieusement au Japon, à Singapour et en Chine", a précisé le Dr Nordmann.
"Pour l'instant on ne sait pas encore la rapidité d'expansion du phénomène (...), s'il s'agit de mois ou d'années, mais ce qui est certain c'est que ça va se diffuser (...), c'est un peu comme une bombe à retardement", a-t-il dit, soulignant l'énorme réservoir que représentent pour ce pathogène les 1,3 milliard d'habitants du sous-continent indien et leur importante diaspora.
Ce "super-pathogène" appelé NDM-1 (New Delhi metallo-lactamase-1) est apparemment originaire d'Inde et a été détecté pour la première fois en 2007 en Grande-Bretagne.
Il est venu à l'attention des médias à la suite d'une étude publiée en août dans la revue médicale britannique The Lancet.
Cette recherche expliquait que ce nouveau pathogène a été ramené en Grande-Bretagne par des "médico-touristes" (patients se faisant opérer à l'étranger) revenant d'Inde.
Un Belge hospitalisé au Pakistan à la suite d'un accident de voiture est la première personne connue à ce jour à y avoir succombé.
js/cel



























